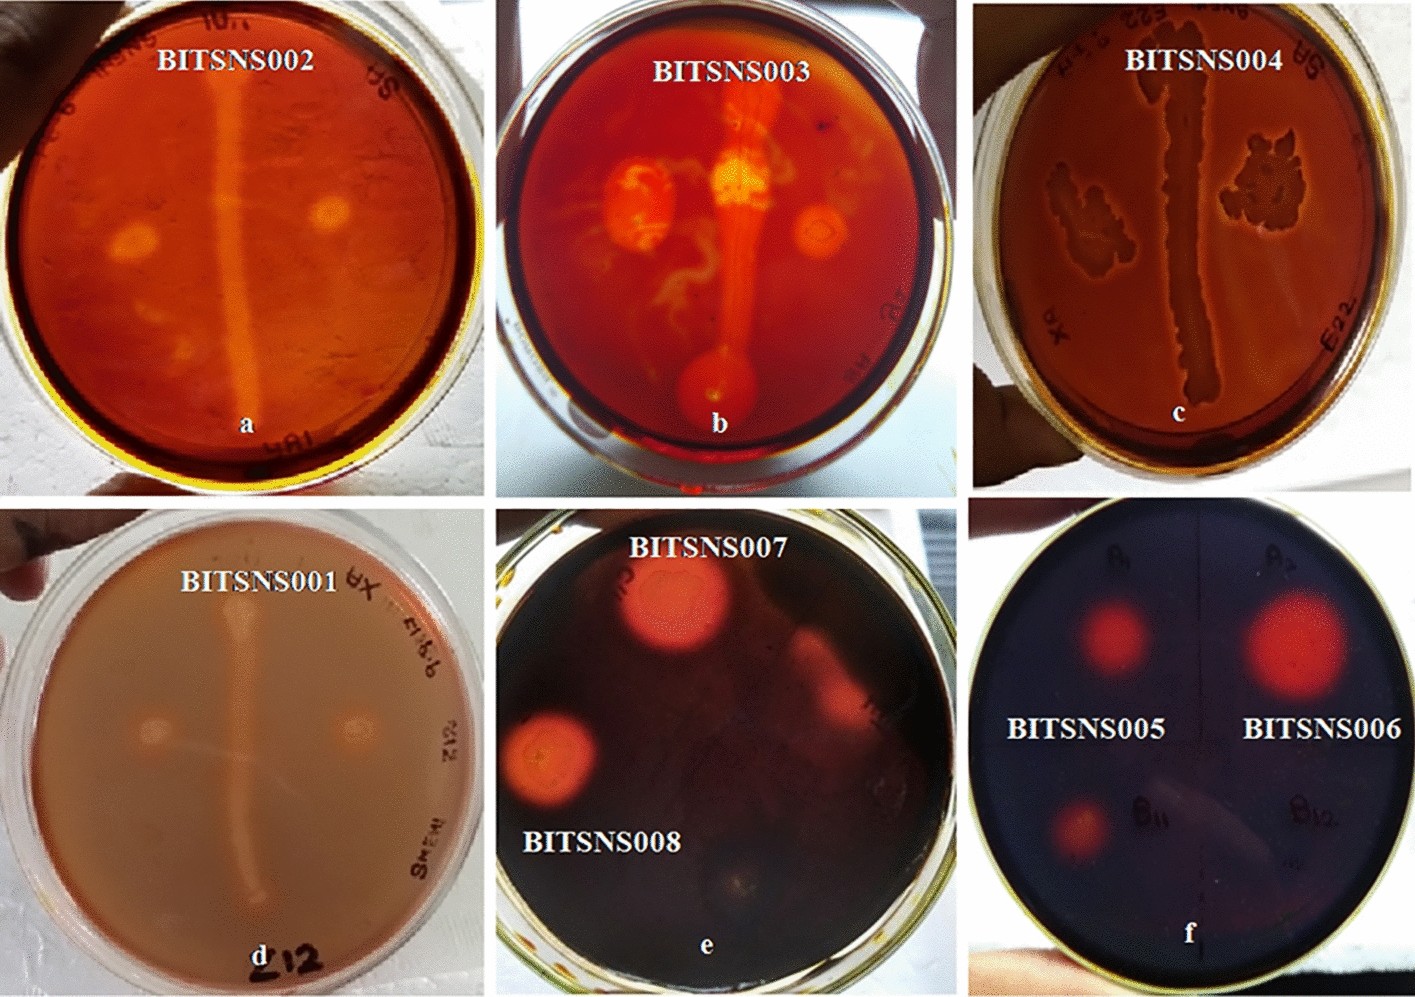
Figure 2

Figure 2

Amylolytic (a–c), xylanolytic (d) and cellulolytic (e–f) activity as hydrolysis zone on media plates for 50 °C isolates.
Amylolytic (a–c), xylanolytic (d) and cellulolytic (e–f) activity as hydrolysis zone on media plates for 50 °C isolates.